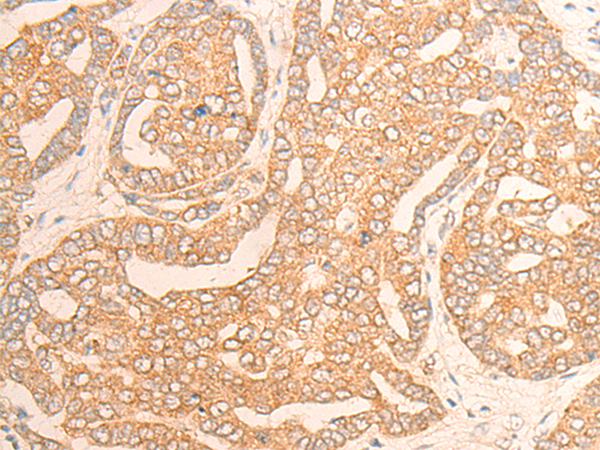

|
Background: |
Members of the AB hydrolase superfamily have diverse catalytic functions and play a crucial role in the metabolism of lipids. DAGLα (diacylglycerol lipase alpha), also known as NSDDR or C11orf11, is a 1,042 amino acid multi-pass membrane protein that belongs to the AB hydrolase superfamily. Highly expressed in brain and pancreas, DAGLα uses calcium as a cofactor to catalyze the hydrolysis of diacylglycerol (DAG) to 2-arachidonoyl-glycerol (2-AG), a reaction that is required for axonal growth and for retrograde synaptic signaling at mature synapses. DAGLα functions as at optimal pH of 7 and its activity is inhibited by p-hydroxy-mercuri-benzoate and HgCl2. The gene encoding DAGLα maps to human chromosome 11, which houses over 1,400 genes and comprises nearly 4% of the human genome. |
|
Applications: |
ELISA, IHC |
|
Name of antibody: |
DAGLA |
|
Immunogen: |
Synthetic peptide of human DAGLA |
|
Full name: |
diacylglycerol lipase alpha |
|
Synonyms: |
NSDDR; C11orf11; DAGLALPHA; DAGL(ALPHA) |
|
SwissProt: |
Q9Y4D2 |
|
ELISA Recommended dilution: |
5000-10000 |
|
IHC positive control: |
Human liver cancer and Human esophagus cancer |
|
IHC Recommend dilution: |
25-100 |

購物車
幫助
021-54845833/15800441009
